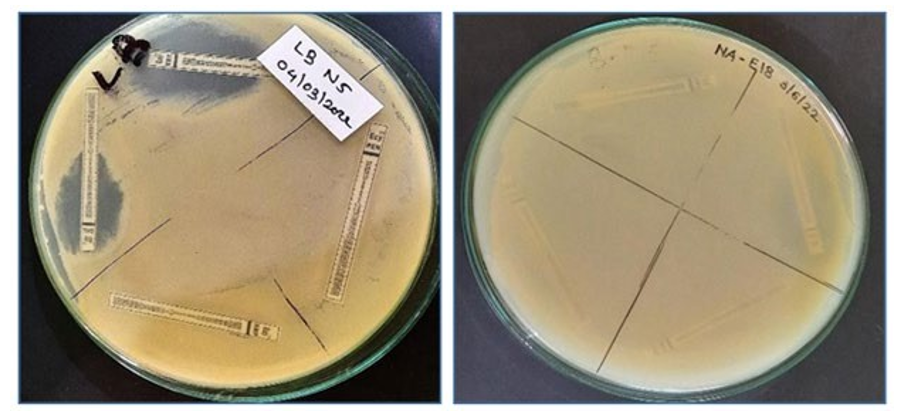

Research Article - (2023) Volume 8, Issue 1
Isolation of Endophytic Bacteria and its Commercial Application as PGP for Sustainable Agriculture to Improve Crop Yield
Received Date: Mar 03, 2023 / Accepted Date: Mar 22, 2023 / Published Date: Mar 28, 2023
Copyright: ©Ghorpade SM, et, al. This is an open-access article distributed under the terms of the Creative Commons Attribution License, which permits unrestricted use, distribution, and reproduction in any medium, provided the original author and source are credited.
Citation: Ghorpade, S. M., Gorwadkar, V. R., Kharmate, A. V. (2023). Isolation of Endophytic Bacteria and its Commercial Application as PGP for Sustainable Agriculture to Improve Crop Yield. Adv Nutr Food Sci, 8(1), 01-10.
Abstract
Background: Utilization of endophytic bacteria in order to increase productivity may be viable alternative to organic fertilizers. The goal is to reduce soil pollution and to preserve environment in the spirit of ecological agriculture. Any organism that at some part of its life cycle, colonize the internal plant tissues without causing any type of harm to the host plant are endophytes. Endophytes are known to promote plant growth and nutrient gain. They may improve the plant’s ability to tolerate various types of abiotic and biotic stresses, and enhance the resistance of plants to insects and pests. This study was carried out to isolate beneficial endophytic bacteria from various sources and to screen and identify plant growth promoting activities of isolated bacteria. Further to study field effects of best found endophytic bacterial isolates and its commercial application. Sources were collected from different regions of Maharashtra such as Geolife Research Farm Pune, Mangrove leaves from Mumbai, Khopoli ghat and examined for their bacterial diversity. Isolated bacteria subjected for various tests such as Indole Acetic Acid production, Ammonia production, Hydrogen Cyanide production, Antibiotic resistance and sensitivity assay, Proteolytic and Amylolytic activities, etc.
Results: In total 34 bacterial isolates were obtained from five different source. Some isolates were found to exhibit multiple beneficial characteristics to promote plant growth. Among them isolate number E14 has shown maximum production of IAA, same isolate also found positive for ammonia production and HCN production. Whereas isolate number E23 obtained from mangrove leaves is showing maximum nitrogen 12.6mg, positive for Ammonia & HCN production and also showing positive results for Amylolytic and Proteolytic activities.
Conclusion: According to field results, the interaction between plant and endophytes can promote plant immunity and play a significant role in sustainable agriculture. Endophytes displaying beneficial traits that can be exploited in agriculture biotechnology.
Keywords
Endophytic Bacteria, Sustainable Agriculture, Plant Immunity Booster, Nitrogen Fixation
Introduction
The endophytic microbes are referred to those microorganisms, which colonize in the interior of the plant parts, viz: root, stem, or seeds without causing any harmful effect on host plant. The word endophyte means “in the plant” and is derived from the Greek words endon (within) and phyton (plant) [1]. Numerous studies in¬dicated that endophytes play important roles in plant disease resis¬tance, secondary metabolites synthesis, plant growth regulations, and environmental stressors withstand [2]. The study of Zgadzaj et al. showed that endophytes and symbiotic nitrogen-fixing bacteria in nodules of leguminous plants jointly improved pathogen resis¬tance ability of host plants [3]. Microbial endophytes can be isolat¬ed from surface-disinfected plant tissue or extracted from internal plant tissues [4]. Endophytic Bacteria represents unique class of bacteria that can colonize interior tissue of plants and provide a range of benefits to the plant similar to those provided by the rhi-zospheric bacteria. Sustainable agriculture and food production for our next generation can be preserved only by protecting different natural resources.
Endophytic microbes can promote plant growth directly through N 2 - fixation; phytohormones production (IAA and gibberellic acids) and solubilization of phosphorus, potassium, and zinc; and production of siderophore or indirectly through inducing resis¬tance to pathogen by production of ammonia, hydrogen cyanide, siderophores, lytic enzymes, and antibiotics. Endophytic microbes may promote plant growth in terms of increased germination rates, biomass, leaf area, chlorophyll content, nitrogen content, protein content, roots and shoot length, yield, and tolerance to abiotic stresses like draught, temperature, flood, salinity, pH, etc. [5, 6].
There are several types of bacterial auxins, and the well-studied of these is indole acetic acid. Many studies have described the ability of endophytic bacteria to produce phytohormones and auxins, such as IAA, and the ability to produce IAA is considered responsible for plant growth promotion by beneficial bacteria [4].
Nitrogen is an essential component of all proteins and enzymes, Nucleic acids that make-up DNA in plants. Much of nitrogen is in the form of dinitrogen (N2), which is inert and cannot be used by plants. In order for plants to use this dinitrogen, it has to be reduced or fixed into forms like Nitrate (NO3-) and ammonium (NH4+). Although the use of fertilizer is invitable in meeting ris¬ing food demand to sustain the growing global population their discriminate use has very negative effects on the environment. Certain endophytic bacteria can provide nitrogen to the plants through biological nitrogen fixation, which is an important source of nitrogen input in agriculture and represents a promising substi-tute for chemical fertilizer.
Phosphorus is the second most important nutrient for plants, af-ter nitrogen. It exists in soil as mineral salts or incorporated into organic compounds. Despite these phosphorus compounds being abundant in agricultural soils, the majority of them occurs in an insoluble form [7]. The unavailability of phosphorus in many soils has been recognized as a major growth-limiting factor in agricul-tural and horticultural systems [8]. Several reports have indicated that different bacterial species, particularly rhizosphere colonizing bacteria, have the ability to liberate organic phosphates or to sol-ubilize insoluble inorganic phosphate compounds such as trical-cium phosphate, dicalcium phosphate, hydroxyapatite, and rock phosphate. These bacteria make available the soluble phosphates to the plants, and in return gain root borne carbon compounds, mainly sugars and organic acids, necessary for bacterial growth [9]. Current research suggests that the inoculation of crops with Phosphate Solubilizing Bacteria (PSB) has the potential to reduce application rates of phosphate fertilizer by 50% without signifi¬cantly reducing crop yield [10].
Potassium (K) is one of the most important macronutrients that requested for plant growth. It is necessary for plant metabolisms such as synthesis of cells, the activity of enzymes, protein and vi-tamin production. Moreover, K increase plant resistance to abiotic and biotic stresses and also regulation of metabolic pathways [11]. In intensive agriculture production, farmer is usually using large amounts of chemical fertilizers, which can cause adverse effects on the environment. Therefore, introduce alternative sources of fertilizer such as microbial activation can be an effective way to reach a sustainable agriculture and to decline the use of chemi¬cal fertilizers [12]. Many studies recently indicate that some en-dophytic bacteria such as Pseudomonas, Bacillus, Klebsiella and Pantoea can release K from insoluble minerals such as mica, illite and others by various mechanisms like organic acid production [13].
Endophytic bacteria are found to synthesis various secondary me¬tabolites such as enzymes, siderophore, hydrogen cyanide etc. Hy¬drogen cyanide (HCN) is a volatile secondary metabolite that is synthesized by many rhizobacteria and has a powerful effect on many organisms. HCN inhibits the electron transport and disrupts the energy supply to the cell, which leads to death of living or¬ganisms. Many bacterial genera have the ability to produce HCN including species of Alcaligenes, Aeromonas, Bacillus, Pseudomo¬nas, and Rhizobium [14]. HCN may affect plant establishment or inhibit development of plant disease, with great potential for con¬trolling plant bacterial diseases [15].
Endophytic bacteria were isolated from different phylum main¬ly: Actinobacteria, Firmicutes, proteobacteria, Bacteroidetes, and Deinococcus-Thermus. The genus Bacillus has been consistently described as culturable and endophytic, and these bacteria can col¬onize wheat, rice, mustard, chili, citrus, and potato [6, 16-20]. The member Bacillus and Bacillus -derived genera (BBDG) associated with different plants showed multifarious plant growth-promoting attributes such as solubilization of phosphorus, potassium, and zinc; production of phytohormones; and biocontrol against differ¬ent pathogens [21]. Pseudomonas, a member of γ- proteobacteria, are ubiquitous in nature and have been also reported from different plant tissues of sugarcane, maize, chili, tomato [22-25].
This study is targeted to isolate mainly Bacillus and Pseudomo¬nas species showing PGP activities since this are used pre-dom-inantly as PGP and biological control agents, for both direct as well as indirect mechanism of plant growth promotion. Members of Bacillus genera are preferred for bio- formulation because of their long shelf/field life, tendency to replicate at faster rate, heat resistant spores, ability to colonize roots rapidly, and several other pre-requisite PGP characteristics. Fluorescent Pseudomonas have also emerged potentially promising group of PGP with their abili¬ty to utilize diverse organic substrates, simple nutritional require¬ment, diverse mechanism of biocontrol which includes antibiotic resistance, HCN production, PGP hormones production, ability to colonize the rhizosphere. Keeping these benefits in mind Bacillus and Pseudomonas study as PGP bacteria has been focused.
In-vitro screening employed to select effective strain of bacteria with multiple PGP activities. Combination of In-vitro and in- vivo screening lead to identification of effective strain for sustainable agriculture. The current study therefore aimed at isolating endo¬phytic bacteria their PGP activity characterization and preliminary screening and some growth effect for maize plant on field. Organic food without synthetic fertilizer and pesticides is more beneficial and nutritious. It contains low level of chemicals; it does not con¬tain genetically modifications and is also better for nature hence growing crops with bio-fertilizer such as endophytes will lead to sustainable agriculture practice to get nutritious and healthy food.
Methodology
Collection of Plant Material
For the isolation of endophytic bacteria source were collected from Geolife Research Farm, Pune which includes leaves of Neem and chilli plant, Roots of Chickpea plant, Root-nodules of Ground-nut plant, leaves & roots of Mangrove from Khopoli Ghat region. Plant guidelines were followed while collecting samples. Samples were collected in clean plastic bag, brought to the laboratory and used for further experimental purpose.
Surface sterilization: The leaves and roots were disinfected super- ficially through the following protocol
1. The collected roots and leaves were wash under running tap water.
2. Tween 20 or Tween 80 for 2 min.
3. Tap water
4. 0.1 % Mercuric chloride for 30 sec
5. Tap water
6. 1% Sodium Hypochlorite for 1min.
7. Sterile water
8. 90% ethanol for 2min.
9. Sterile water
10. Grinding the roots and leaves using Morter and Pestle
Isolation and Purification of Bacteria
The choice of the growth medium is crucial as it directly affects to the number and type of endophytic microorganism that can be iso¬lated from the selected source. Nutrient agar and Kings B medium were used for the isolation of endophytic bacteria. Since there is no component in NA and KB which can suppress growth of endo¬phytic fungi so the media were used for the isolation of endophytic bacteria were supplemented with an antifungal agent Amphoteri-cin B at a concentration of 100µg/ml to suppress fungal growth.
After surface sterilization samples were macerated using mort¬er and pestle and 1ml of sample was enriched in 100ml Nutrient broth and Kings B broth for 24hrs. Isolation of endophytes was made by following serial dilutions & pour plate method using the specific KB & NA medium. 1ml of broth suspension from aliquote dilution was aseptically added to sterile petri dishes containing the sterile medium & incubated at 28áµ?C for 48 hrs. After incubation, well separated individual colonies were marked & were picked up under aseptic condition purified and maintain on same medium at 4áµ?C for further studies Figure 1. Morphological assays of the isolated bacteria were done using direct microscopic examination of bacterial isolates for studying the shape of bacterial cells and gram staining.
Figure 1: Streak plate and microscopic observation of Gram staining
Phosphate Solubilizing Activity
To study phosphate-solubilizing efficiency of isolated bacteria, colonies were spot inoculated on Pikovskaya’s agar plates. The plates were incubated for 2 days at 30áµ?C and observed for solubi-lization. Phosphate solubilization is indicated by the formation of clear zone around the colonies. The size of phosphate solubilizing zone was measured for each colony Figure 2D.
Potassium Mobilizing Activity
Potassium mobilizing activity of isolated bacteria was the colonies were pick and spot inoculated on Aleksandrow agar plates. The plates were incubated for 2 days at 30áµ?C. A clear zone around the colony was consider as positive for potassium mobilization Figure 2C.
HCN Production
All the isolates were screened for production of HCN by using the method of Lorck. Briefly, nutrient agar was amended with 4.4 g Glycine/L and isolates were streaked on modified agar plates. Each plate overlaid with whaman paper no. 2 that was impregnated with 0.5% picric acid and 2% sodium carbonate. Plates were sealed with parafilm and incubated at 28áµ?C ± 2áµ?C for 24hrs. Change of color from yellow to orange- brown color on the filter paper is an indicator to HCN production Figure 2F.
Figure 2: PGP activities A. Starch Hydrolysis B. Casein Hydrolysis C.KMB D. PSB E. Ammonia production F.HCN Production
Nitrogen Fixation
All the bacterial samples were inoculated to the N2 free mannitol broth and incubated for 3 days. After incubation culture, broth was subjected for nitrogen estimation by the Kjeldahl method.
Detection and Estimation of IAA
For screening of Indole acetic acid producing isolates, test culture was inoculated in Luria Bertani broth amended with Tryptophan conc. of 1.5 g/100ml and incubated at room temperature for 3 days. Cultures were centrifuged at 2000 rpm for 2min and supernatant was collected. 1 ml of supernatant mixed with 1 ml of Solkowski’s reagent (50 ml-35% perchloric acid; 1ml 0.5M FeCl3). Develop¬ment of pink color indicated the production of Indole acetic acid. In Figure 3 Optical density was recorded at 530nm and quantity of IAA produced was estimated from standard curve of IAA.
Figure 3: Qualitative estimation of IAA
Ammonia Production
Bacterial isolates were tested for the production of ammonia in peptone water. Freshly grown cultures were inoculated in 10ml peptone water in each tube and incubated for 48 hrs at 28áµ?C.Nessler’s reagent was added in each tube. Development of yellow to brown color indicated a positive test for ammonia production Figure 2E.
Enzyme Production
To study protease and amylase enzyme production casein hydroly¬sis and starch hydrolysis method was followed.
1. Protease: All the bacterial isolates were screened for proteolytic activity on skim milk agar plates. Bacterial isolates were streaked on skim milk agar plates and plates were incubated at 28áµ?C for 24hrs and observed for proteolysis i.e clear zone produced around the bacterial colony Figure 2B.
2. Amylase: All the bacterial isolates were screened for starch hy-drolysis. Isolates were streaked on starch hydrolysis agar plates and incubate at 28áµ?C for 2 days. After 48hrs the iodine solution was added to the plates and check the zone around colony results were observed and recorded Figure 2A.
Antibiotic Resistance and Sensitivity Assay
Isolates, which are showing efficient results, are subjected for an¬tibiotic assay. All isolates were grown in NB and KB broth respec¬tively for 48 hrs. After incubation freshly grown 500µl sample was evenly spread on NA and KB agar and antibiotic strips with lower to higher concentration range were placed on plate aseptically and incubated it for 48hrs. After incubation, plates were observed Fig¬ure 4 and results were recorded.
Figure 4: Antibiotic resistance and sensitivity assay of Isolate number E5 and E18
Field Trial
To study in vitro potential of isolated bacteria as PGP field tri¬al was carried out. For field trail each isolate was grown in their respective broth for 48hrs and then samples were taken to field. Seeds were sown in bags with three replications for each isolate. Application of freshly grown endophytic isolates were done at 15 days after sowing. Samples were prepared based on doses for each treatment. Firstly, foliar spray was done then rest of solution were drenched to the pots of particular treatment. Other crop manage¬ment practices like irrigation, nutrition and pest disease manage¬ment were same for all the treatments including control. After 15 days results were recorded Table 1
Table 1: Field trial for plant growth promotion Rank A: Growth difference over control more than 100% Rank B: Growth difference over control more than 75% Rank C: Growth difference over control more than 50% Rank D: Growth difference over control more than 25% Rank E: Growth difference over control less than 25%
|
Isolate number |
Leaves |
Height |
Average |
Rank |
|
E4 |
0.00 |
15.49 |
7.75 |
E |
|
E5 |
43.75 |
68.29 |
56.02 |
C |
|
E6 |
62.50 |
109.76 |
86.13 |
B |
|
E10 |
75 |
97.56 |
86.28 |
B |
|
E13 |
75 |
85.37 |
80.18 |
B |
|
E14 |
75 |
131.71 |
103.35 |
A |
|
E15 |
50 |
90.24 |
70.12 |
C |
|
E16 |
87.50 |
117.07 |
102.29 |
A |
|
E18 |
68.75 |
100 |
84.38 |
B |
|
E21 |
75 |
75.61 |
75.30 |
B |
|
E23 |
31.25 |
53.66 |
42.25 |
D |
|
E25 |
56.25 |
82.93 |
69.59 |
C |
|
E31 |
62.50 |
100 |
81.24 |
B |
|
E29 |
75 |
107.32 |
91.16 |
B |
|
E26 |
50 |
80.49 |
65.24 |
C |
|
E33 |
50 |
78.05 |
64.02 |
C |
|
E34 |
56.25 |
58.54 |
57.39 |
C |
Result
In total 34 isolates were obtained from all 5 samples among them 8 isolates were obtained from Neem leaves, 2 from chilli leaves, 7 from Groundnut nodules and 2 from Chick-pea roots and 15 from mangrove. Colony characteristics such as Shape, Size, and Color, Margin, Elevation, Opacity and consistency were studies. Characteristics were found significantly different from each other Table 2.
Table 2: Colony characteristics and Gram’s nature of isolates obtained
|
Sample |
Isolate Code |
Media Used |
Colony Characteristics |
Gram Staining |
Gram Staining |
||
|
Shape |
Margin |
Margin |
|||||
|
Neem Leaves |
E4 |
NA |
Irregular |
Uneven |
Creamy White |
Negative |
Short Rods |
|
E5 |
NA |
Circular |
Even |
Off White |
Positive |
Rods In Chains |
|
|
E8 |
KB |
Circular |
Entire |
Green |
Negative |
Short Rods |
|
|
Chilli leaves |
E10 |
NA |
Circular |
Entire |
Creamy White |
Positive |
Short Rods |
|
Chick –pea Roots |
E14 |
NA |
Circular |
Entire |
Creamy White |
Positive |
Rods |
|
E15 |
NA |
Circular |
Uneven |
White |
Positive |
Rods |
|
|
Groundnut Nodules |
E16 |
NA |
Circular |
Entire |
White |
Positive |
Rods |
|
E18 |
NA |
Circular |
Uneven |
Off White |
Positive |
Rods |
|
|
Mangrove leaves |
E25 |
NA |
Circular |
Uneven |
Creamy white |
Positive |
Rods |
|
E34 |
KB |
Circular |
Uneven |
Light green |
Negative |
Short rod |
|
Enzyme production tests were performed to screen all 34 endo-phytic isolates obtained among them 12 isolates had shown zone on starch agar plate after addition of iodine which indicates posi-tive results for amylase production. 18 isolates had shown zone of clearance on casein hydrolysis media. (Table 3) Endophytes iso¬lated from roots, nodules and mangrove showed positive results for potassium mobilization isolate no E21 had shown highest zone (23mm) on Aleksandrow agar media. Endophytic bacteria E10 isolated from chilly leaves, E18 from groundnut nodules and E21 and E25 from mangrove leaves were able to solubilize phosphate. Results for ammonia production were quite good for all isolates and total 16 isolates had shown maximum production of ammonia except isolate E3 and E13 both were found negative for ammo¬nia production as no color change was observed after addition of Nessler’s reagent. According to results of Kjeldahl isolate number E23 saw method 12.6 mg maximum nitrogen fixation.
Out of 34 endophytic bacteria, 13 isolates were able to produce IAA. Isolate number E14 shown maximum production of IAA fol¬lowed by E15 and E31. For HCN production 30 isolates had shown color change from yellow to brown indicates positive results.
Table 3: Results for plant growth promotion properties where, +: Positive results ++: maximum production-: Negative results
|
Isolate Number |
Amylase |
Protease |
Potassium |
Phosphate |
Ammonia |
Nitrogen |
HCN |
|
E4 |
+ |
+ |
- |
- |
++ |
8.4mg |
+ |
|
E7 |
- |
- |
- |
- |
++ |
8.4mg |
- |
|
E8 |
- |
- |
- |
- |
+ |
4.2mg |
- |
|
E12 |
- |
- |
- |
- |
++ |
4.2mg |
+ |
|
E14 |
- |
- |
+ |
- |
- |
8.4mg |
+ |
|
E15 |
- |
- |
+ |
- |
++ |
8.4mg |
+ |
|
E16 |
+ |
+ |
- |
- |
+ |
12 mg |
++ |
|
E18 |
- |
+ |
+ |
+ |
+ |
8.4mg |
+ |
|
E19 |
- |
- |
+ |
- |
+ |
8.4mg |
++ |
|
E21 |
- |
- |
+ |
+ |
+ |
4.2mg |
+ |
|
E23 |
+ |
+ |
- |
- |
+ |
12.6mg |
+ |
|
E25 |
- |
+ |
- |
+ |
++ |
4.2mg |
+ |
|
E26 |
+ |
+ |
+ |
- |
+ |
4.2mg |
+ |
|
E31 |
- |
+ |
+ |
- |
+ |
8.4mg |
- |
|
E34 |
- |
+ |
- |
- |
+ |
8.4mg |
+ |
Qualitative and Quantitative estimation of IAA
In presence of 1% tryptophan, production of IAA by selected isolates was observed using Salkowski’s reagent. Both qualitative and quantitative results obtained are as follows (Table 4). Isolates E14, E1, E15 and E11 showed highest production of IAA
Table 4: Qualitative and Quantitative estimation of IAA
|
Sample Name |
Qualitative |
Quantitative |
|
Color Appearance |
Concentration µg |
|
|
E-11 |
Red |
385.86 |
|
E-12 |
Yellow |
-2.09 |
|
E-13 |
Red |
308.66 |
|
E-14 |
Dark Red |
614.26 |
|
E-15 |
Dark Red |
502.26 |
|
E-16 |
Red |
82.66 |
|
E-17 |
Red |
574.86 |
|
E-18 |
Orange |
-18.22 |
|
E-19 |
Yellow |
-4.17 |
|
Control |
Yellow |
00 |
Antibiotic Resistance and Sensitivity Assay
All the isolates obtained were screened for antibiotic resistance and sensitivity assay. Among them most of the isolates were found re- sistant to selected antibiotics ampicillin, penicillin chloramphenicol, and erythromycin (Table 5)
Table 5: Antibiotic resistance and sensitivity assay where R- Resistant against low concentration, RR - Resistant against lower as well ashigher concentration
|
Isolate number |
AMP |
PEN |
CHL |
ERY |
|
E2 |
R |
RR |
R |
R |
|
E4 |
RR |
RR |
R |
R |
|
E5 |
RR |
RR |
R |
R |
|
E8 |
RR |
RR |
R |
R |
|
E9 |
R |
R |
R |
R |
|
E11 |
R |
RR |
R |
R |
|
E17 |
RR |
RR |
R |
R |
|
E18 |
RR |
RR |
R |
RR |
|
E19 |
RR |
RR |
R |
RR |
Field Trial Results for Plant Growth Promotion
The present study was under taken for screening of different endophytes for growth and development of maize. During the experiment, observations were recorded on different morphological parameters of maize. The results obtained from the study are presented as fol¬lows. Figure 5.
Figure 5: A. Field trial of endophytes on maize plant B. Control and endophyte treated plant
Discussion
This study is to describe indigenous bacterial endophytes isolated from various plant materials. The diversity of a collection of 34 endophytic bacteria isolated from different tissue of selected plant was assessed using phenotypic characterization methods. In our study, endophytic bacterial population was found highest in man¬grove leaves and roots sample, it might be due to its habitat and biotic environment containing alkaline water, heavy metals etc.
Colony morphology gave an indication of the variation among the endophytes. The isolates were chosen for their uniqueness or differences with other in colony morphology. Interestingly, gram positive and gram-negative isolates were equally distributed be-tween two species bacillus and pseudomonas. This results of colo-ny morphology and gram staining indicated that 11 isolates might be bacillus and 10 isolates showing similar characteristics to pseu¬domonas.
Our enzyme production result evaluates the function and per-sistence of endophytic bacteria in various tissue generally showed common traits for pectinase and amylase. Hydrolytic enzyme may play important role in mechanism by which endophytic bacteria penetrate into and persist in host plant. The 30 HCN producing isolates were isolated. A strong HCN production was recorded by isolate no E16 and E19.
Among 34 bacterial isolates, 4 isolates showed positive results for phosphate solubilization. Isolate E21 was able to solubilize maximum phosphorus and showed 20mm zone of solubilization. Whereas 14 isolates were found positive for potassium mobiliza-tion. Isolate E14, E21 and E31 showed 25mm, 23mm and 21mm zone of potassium mobilization. This will help to provide phos-phorus and potassium in usable form to crops.
The growth stimulation by the endophytic microbes can be conse¬quence of nitrogen fixation, out of 34 endophytic bacterial isolates obtained, 31 isolates were able to fix nitrogen. Results of Isolate E23 showed highest 12.6mg nitrogen fixation followed by isolate E16 showed 12mg. this biological nitrogen fixation will be better alternative for the chemical fertilizer in order to achieve sustain¬able agriculture to meet increasing food demand.
Results of qualitative and quantitative estimation of IAA reveals that isolate E14 was able to produce highest amount of IAA (614.26µg/ml) among all tested isolates. This clearly suggests that the isolated endophytic bacteria are able to produce plant growth hormones in higher concentration.
Collectively field trial results indicated that the use of PGP endo¬phytic isolates E16 and E14 as inoculants is beneficial for maize and also for other crop cultivation as they enhanced growth of maize on field due to its abilities such as growth hormone produc¬tion, nitrogen fixation, potassium mobilization, phosphate solubi¬lization and can be due to plant protection from pathogens with the help of enzyme and secondary metabolite production.
Results indicates that endophytes works in two different ways, first is direct plant growth promotion which involves solubilization of Phosphate & Potassium, Growth Hormone production Nitrogen fixation helps in plant growth and yield. Another is indirect plant growth promotion via production of Ammonia, HCN and hydro-lytic enzymes improves plant health and protection. Hence, en-dophytes work as plant probiotics and can be used to immunity booster for sustainable agriculture.
In rise of global population to meet highly increasing demand of healthy food and to reduce use of harmful chemical fertilizer, con-sidering good impact of PGP endophytes in terms of bio fertiliza-tion all of which exert a positive influence on crop productivity, encouragement should be given to its implementation in agricul-ture. Endophytes are good tool for enhancement of plant growth, improvement of quality and yield of plant products. For betterment of technology in developing research, endophytic PGP bacteria will surely become a process to ensure stability and productivity of agro-ecosystem, thus leading to ideal agriculture.
Future Prospects
Molecular study of isolated endophytes is important in order to improve drug research. It is also important to study diversity of endophytes and their specie identification. Molecular biology techniques can be used for the identification of different types of genes present in biosynthetic pathways and this will further open doors to new bioactive compounds at a commercial level. Future study should also focus on biosynthetic pathways, which might be responsible for the secretion of numerous important bioactive compound by endophytes.
Author’s Contribution
The authors confirm contribution to the paper as follows: Ghor-pade SM study conception and design, interpretation of results and contributed to manuscript writing, Gorwadkar VR data collection, contributed for data or analysis tools, performed analysis, manu-script preparation, and Kharmate AV Performed data analysis and contributed for analysis tools. All authors reviewed the results and approved final version of manuscript.
References
- Suman, A., Yadav, A. N., & Verma, P. (2016). Endophytic microbes in crops: diversity and beneficial impact for sustainable agriculture. Microbial inoculants in sustainable agricultural productivity: Vol. 1: research perspectives, 117-143.
- Coombs, J. T., & Franco, C. M. (2003). Isolation and identification of actinobacteria from surface-sterilized wheat roots. Applied and environmental microbiology, 69(9), 5603-5608.
- Zgadzaj, R., James, E. K., Kelly, S., Kawaharada, Y., de Jonge, N., Jensen, D. B., ... & Radutoiu, S. (2015). A legume genetic framework controls infection of nodules by symbiotic and endophytic bacteria. PLoS Genetics, 11(6), e1005280.
- Hallmann, J., Quadt-Hallmann, A., Mahaffee, WF, & Kloep-per, JW (1997). Bacterial endophytes in agricultural crops. Canadian journal of microbiology , 43 (10), 895-914.
- Rosenblueth, M., & Martínez-Romero, E. (2006). Bacterial endophytes and their interactions with hosts. Molecular plant-microbe interactions, 19(8), 827-837.
- Verma, P., Yadav, A. N., Kazy, S. K., Saxena, A. K., & Su-man, A. (2013). Elucidating the diversity and plant growth promoting attributes of wheat (Triticum aestivum) associated acidotolerant bacteria from southern hills zone of India. Natl J Life Sci, 10(2), 219-226.
- Miller, S. H., Browne, P., Prigentâ?Combaret, C., Combesâ?Meynet, E., Morrissey, J. P., & O’Gara, F. (2010). Biochemical and genomic comparison of inorganic phosphate solubilization in Pseudomonas species. Environmental microbiology reports, 2(3), 403-411.
- Daniels, C., Michán, C., & Ramos, J. L. (2009). New molecular tools for enhancing methane production, explaining thermodynamically limited lifestyles and other important bio-technological issues. Microbial biotechnology, 2(5), 533-536.
- Khan, M. S., Zaidi, A., Ahemad, M., Oves, M., & Wani, P.A. (2010). Plant growth promotion by phosphate solubilizing fungi–current perspective. Archives of Agronomy and Soil Science, 56(1), 73-98.
- Jilani, G., Akram, A., Ali, R. M., Hafeez, F. Y., Shamsi, I. H., Chaudhry, A. N., & Chaudhry, A. G. (2007). Enhancing crop growth, nutrients availability, economics and beneficial rhizosphere microflora through organic and biofertilizers. Annals of Microbiology, 57, 177-184.
- Epstein, E., & Bloom, A. J. (2005). Mineral nutrition of plants:principles and perspectives, 400. New York, NY: Sinnauer.
- Bakhshandeh, E., Rahimian, H., Pirdashti, H., & Nematza-deh, G. A. (2015). Evaluation of phosphateâ?solubilizing bacteria on the growth and grain yield of rice (Oryza sativa L.) cropped in northern Iran. Journal of applied microbiology, 119(5), 1371-1382.
- Meena, V. S., Maurya, B. R., Verma, J. P., Aeron, A., Kumar, A., Kim, K., & Bajpai, V. K. (2015). Potassium solubilizing rhizobacteria (KSR): isolation, identification, and K-release dynamics from waste mica. Ecological Engineering, 81, 340-347.
- Alemu, F. (2016). Isolation of Pseudomonas flurescens from rhizosphere of faba bean and screen their hydrogen cyanide production under in vitro study, Ethiopia. Am J Life Sci, 4(2), 13-19.
- Lanteigne, C., Gadkar, V. J., Wallon, T., Novinscak, A., & Fil-ion, M. (2012). Production of DAPG and HCN by Pseudomonas sp. LBUM300 contributes to the biological control of bacterial canker of tomato. Phytopathology, 102(10), 967-973.
- Sun, L., Qiu, F., Zhang, X., Dai, X., Dong, X., & Song, W. (2008). Endophytic bacterial diversity in rice (Oryza sativa L.) roots estimated by 16S rDNA sequence analysis. Microbial ecology, 55, 415-424.
- Sheng, X. F., Xia, J. J., Jiang, C. Y., He, L. Y., & Qian, M. (2008). Characterization of heavy metal-resistant endophytic bacteria from rape (Brassica napus) roots and their potential in promoting the growth and lead accumulation of rape. Environmental pollution, 156(3), 1164-1170.
- Rasche, F., Trondl, R., Naglreiter, C., Reichenauer, T. G., & Sessitsch, A. (2006). Chilling and cultivar type affect the diversity of bacterial endophytes colonizing sweet pepper (Cap-sicum anuum L.). Canadian journal of microbiology, 52(11),1036-1045.
- Araújo, W. L., Maccheroni Jr, W., Aguilar-Vildoso, C. I., Bar-roso, P. A., Saridakis, H. O., & Azevedo, J. L. (2001). Variability and interactions between endophytic bacteria and fungi isolated from leaf tissues of citrus rootstocks. Canadian journal of microbiology, 47(3), 229-236.
- Sessitsch, A., Reiter, B., & Berg, G. (2004). Endophytic bacterial communities of field-grown potato plants and their plant-growth-promoting and antagonistic abilities. Canadian journal of microbiology, 50(4), 239-249.
- Tilak, K. V. B. R., Ranganayaki, N., Pal, K. K., De, R., Saxe-na, A. K., Nautiyal, C. S., ... & Johri, B. N. (2005). Diversity of plant growth and soil health supporting bacteria. Current science, 136-150.
- Suman, A., Shrivastava, A. K., Gaur, A., Singh, P., Singh, J., & Yadav, R. L. (2008). Nitrogen use efficiency of sugarcane in relation to its BNF potential and population of endophyticdiazotrophs at different N levels. Plant Growth Regulation, 54, 1-11.
- Thanh, D. T. N., & Diep, C. N. (2014). Isolation, characterization and identification of endophytic bacteria in maize (Zea mays L.) cultivated on Acrisols of the Southeast of Vietnam. Am J Life Sci, 2(4), 224-233.
- Kang, S. H., Cho, H. S., Cheong, H., Ryu, C. M., Kim, J. H.,& Park, S. H. (2007). Two bacterial entophytes eliciting both plant growth promotion and plant defense on pepper (Capsi-cum annuum L.). Journal of microbiology and biotechnology, 17(1), 96-103.
- Kumar, K., Amaresan, N., Bhagat, S., Madhuri, K., & Srivastava, R. C. (2011). Isolation and characterization of rhizobacteria associated with coastal agricultural ecosystem of rhizosphere soils of cultivated vegetable crops. World Journal of Microbiology and Biotechnology, 27, 1625-1632.
